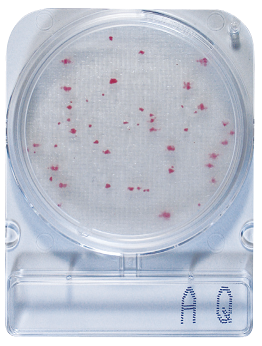

CompactDry AQ 水質總生菌(異營菌)乾式測試片
●專有薄膜材質,樣品自動平均分散
●乾式培養基,可放常溫保存
●特殊呈色基質,易於判讀
●三大國際認證,品質穩定有保證
●輕巧方便、節省培養空間
●產品線齊全,把關檢測守門員
價格:請洽詢
更多資訊
↓↓↓↓
●乾式培養基,可放常溫保存
●特殊呈色基質,易於判讀
●三大國際認證,品質穩定有保證
●輕巧方便、節省培養空間
●產品線齊全,把關檢測守門員
價格:請洽詢
更多資訊
↓↓↓↓


Compact Dry AQ 水質總生菌(異營菌)乾式測試片
Compact Dry AQ (Water Heterotrophic bacteria,AQ) 水質總生菌(異營菌)乾式測試片,為日本島津(Shimadzu Diagnostics Corporation)所研發的乾式培養基( Compact Dry ),Compact Dry突破微生物培養基無法常溫保存的限制,讓產品可於常溫保存長達1年。
Compact Dry AQ 水質總生菌(異營菌)乾式測試片操作過程中不須壓版,其獨特立體纖維材質在接種後,會自動向外擴散且不滲漏,不僅操作方便省時,內建的網格可有效簡化計數程序,且體積更小於一般培養皿,可無限次疊加。
Compact Dry AQ 水質總生菌(異營菌)乾式測試片於日本製造,符合ISO9001 / ISO13485 / ISO14001規範,品質製程安心又可靠。


產品規格 :
40片/組;6組/箱
保存條件 :
常溫乾燥陰涼處即可
測試條件 :

1. 待測樣品稀釋後,進行增殖培養
2. 培養增殖液滴入測試片後,以36±2℃進行培養44±4hr
3. 取出測試片即可判讀
結果判讀 :
觀察重點:
培養基中含有特殊發色基質,Water Heterotrophic bacteria會長成紅色菌落

